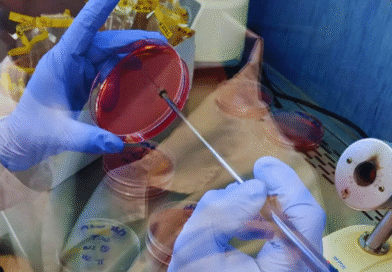
Laboratorio del INTA se integra a la RedLab para fortalecer el control sanitario avícola Laboratorio del INTA se integra a la RedLab para fortalecer el control sanitario avícola

Agricultura

Estudian semillas nativas para restaurar ambientes
Un equipo del IPAF Pampeano del INTA realizó una investigación sobre el comportamiento de semillas de chal-chal —Allophylus edulis— y
Eventos

Nuestros Caballos: el gran encuentro del mundo ecuestre vuelve a La Rural.
Se desarrollará del 24 al 29 de marzo de 2026 y contará con una agenda repleta de actividades. · Una
Ganadería

Bovino Criollo, entre las razas con resistencia natural a la garrapata
Estudios realizados por especialistas del INTA demostraron que esta raza presenta una marcada resistencia genética a la garrapata común del
Producción

La industria láctea argentina pasa de la resiliencia a la eficiencia y optimización
Según el último informe de mercado de Quarterra, la producción de leche en Latinoamérica experimentó un fuerte crecimiento hasta finales de